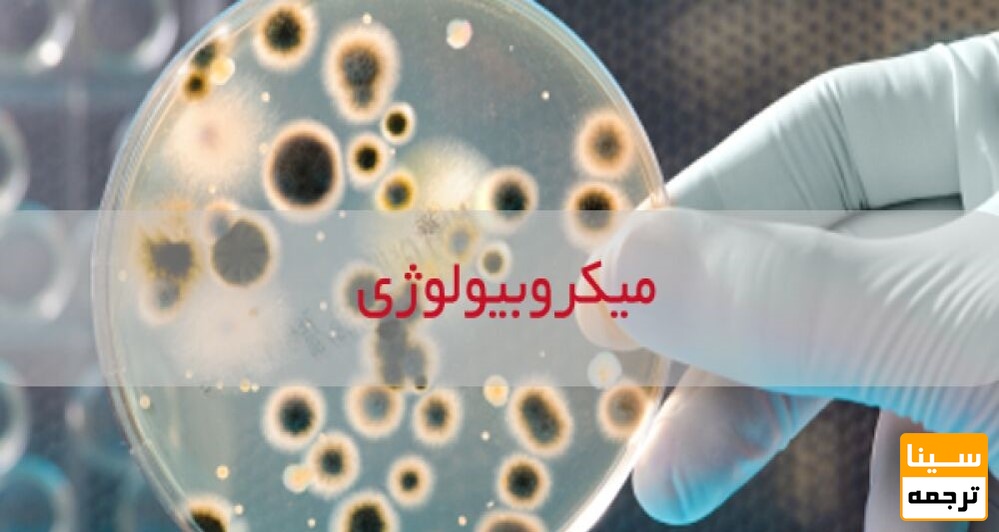

سینا ترجمه
سینا ترجمه: برای دسترسی آسان دانشجویان رشته میکروبیولوژی به لیست مجلات مرتبط با رشته خود، موسسه سینا ترجمه لیست مجلات رشته میکروبیولوژی را بصورت فایل قابل دانلود در این بخش قرار داده است.
میکروبیولوژی یکی از بنیادیترین شاخههای علوم زیستی است که نقش مستقیمی در پیشرفت پزشکی، داروسازی، صنایع غذایی، بیوتکنولوژی و بهداشت عمومی دارد. انتشار مقالات پژوهشی در مجلات ISI میکروبیولوژی به پژوهشگران این امکان را میدهد تا یافتههای خود را در سطح بینالمللی مطرح کرده و در نظامهای ارزیابی دانشگاهی و پژوهشی امتیازات علمی بالاتری کسب کنند. در این محتوا، ضمن معرفی جایگاه علمی میکروبیولوژی، به اهمیت چاپ مقاله در مجلات ISI، معرفی حوزههای تخصصی و ارائه لیست مجلات معتبر پرداخته میشود.
میکروبیولوژی به بررسی میکروارگانیسمها از جمله:
باکتریها
ویروسها
قارچها
انگلها
میکروارگانیسمهای پروکاریوت و یوکاریوت ساده
میپردازد و بهعنوان یکی از ارکان اصلی تحقیقات زیستی و پزشکی شناخته میشود. بسیاری از دستاوردهای نوین علمی، از تولید واکسنها تا درمانهای هدفمند، ریشه در پژوهشهای میکروبیولوژی دارند.

چاپ مقاله در مجلات نمایهشده در Institute for Scientific Information مزایای قابل توجهی دارد:
افزایش اعتبار علمی مقاله در سطح جهانی
امکان استناد بیشتر توسط محققان بینالمللی
کسب امتیاز پژوهشی برای مصاحبه دکتری و ارتقاء هیئت علمی
تأیید کیفیت علمی تحقیق توسط داوران تخصصی
افزایش شانس همکاریهای پژوهشی و گرنتهای تحقیقاتی
در بسیاری از دانشگاهها، مجلات ISI معیار اصلی سنجش کیفیت پژوهش محسوب میشوند.
Medical Microbiology
Clinical Microbiology
Environmental Microbiology
Food Microbiology
Industrial Microbiology
Molecular & Cellular Microbiology
Virology و Bacteriology
Antimicrobial Resistance
شناخت دقیق گرایش مقاله، نقش کلیدی در انتخاب ژورنال مناسب دارد.

در این بخش، لیست مجلات معتبر ISI در حوزه میکروبیولوژی ارائه میشود که برای چاپ مقالات پژوهشی، مروری و کاربردی مناسب هستند.

برای افزایش شانس پذیرش مقاله میکروبیولوژی، به موارد زیر توجه کنید:
هر مجله تمرکز مشخصی دارد؛ ارسال مقاله خارج از این محدوده منجر به Desk Reject میشود.
مقالات تجربی ساده معمولاً برای مجلات با IF بسیار بالا مناسب نیستند.
برخی ژورنالها فقط Original Article میپذیرند و برخی Review یا Short Communication.
داوران این حوزه معمولاً بر موارد زیر تمرکز دارند:
طراحی صحیح آزمایشها
روشهای کشت و شناسایی میکروارگانیسمها
تحلیل آماری دقیق دادهها
نوآوری در روش یا یافتهها
رعایت اصول اخلاق پژوهش
عدم توضیح کامل روشهای آزمایشگاهی
استفاده از منابع قدیمی و نامعتبر
نگارش ضعیف بخش Results و Discussion
انتخاب ژورنال نامرتبط با گرایش مقاله
بیتوجهی به فرمت و دستورالعمل نویسندگان

موسسه سینا ترجمه با ارائه خدمات تخصصی معرفی رایگان مجله، فرصتی ارزشمند برای پژوهشگران در تمامی رشتهها و حوزههای علمی فراهم کرده است. پس از دریافت چکیده مقاله، تیمی از کارشناسان مجرب در رشته مربوطه، با دقت و دانش تخصصی، مناسبترین و معتبرترین مجلات بینالمللی را متناسب با موضوع و سطح مقاله معرفی میکنند. این خدمت با درنظر گرفتن نمایههای معتبر، فرایند داوری و اهداف هر مجله ارائه میشود تا شانس پذیرش مقاله بهطور چشمگیری افزایش یابد. علاوه بر این، موسسه سینا ترجمه با برخی مجلات معتبر خارجی همکاری مستقیم دارد که این امکان را فراهم میسازد تا پذیرش مقاله در درصد بالایی برای نویسنده تضمین گردد. این خدمت، راهکاری حرفهای و مطمئن برای انتخاب مجله علمی مناسب و چاپ موفق مقاله در سطح بینالمللی است.
جهت اطلاعات بیشتر برای دریافت مجلات داخلی و خارجی میتوانید با کارشناسان ما از طریق تماس یا پست الکترونیکی موسسه و همچنین از طریق شبکههای مجازی (واتسپ، اینستاگرام، تلگرام و ایتا) در ارتباط باشید و یا از طریق لینک زیر سفارش خود را ثبت نمایید.

راههای ارتباطی با ما
در صورت داشتن نوآوری یا کاربرد مشخص، بله؛ اما برای مجلات Q1 نیاز به ارزش افزوده علمی بالاتری است.
مجلات JCR دارای ایمپکت فاکتور هستند، اما ISI Listed بدون ایمپکت نیز معتبر و قابل استنادند.
بله، نگارش ضعیف حتی در مقالات با دادههای قوی میتواند منجر به ریجکت شود.
